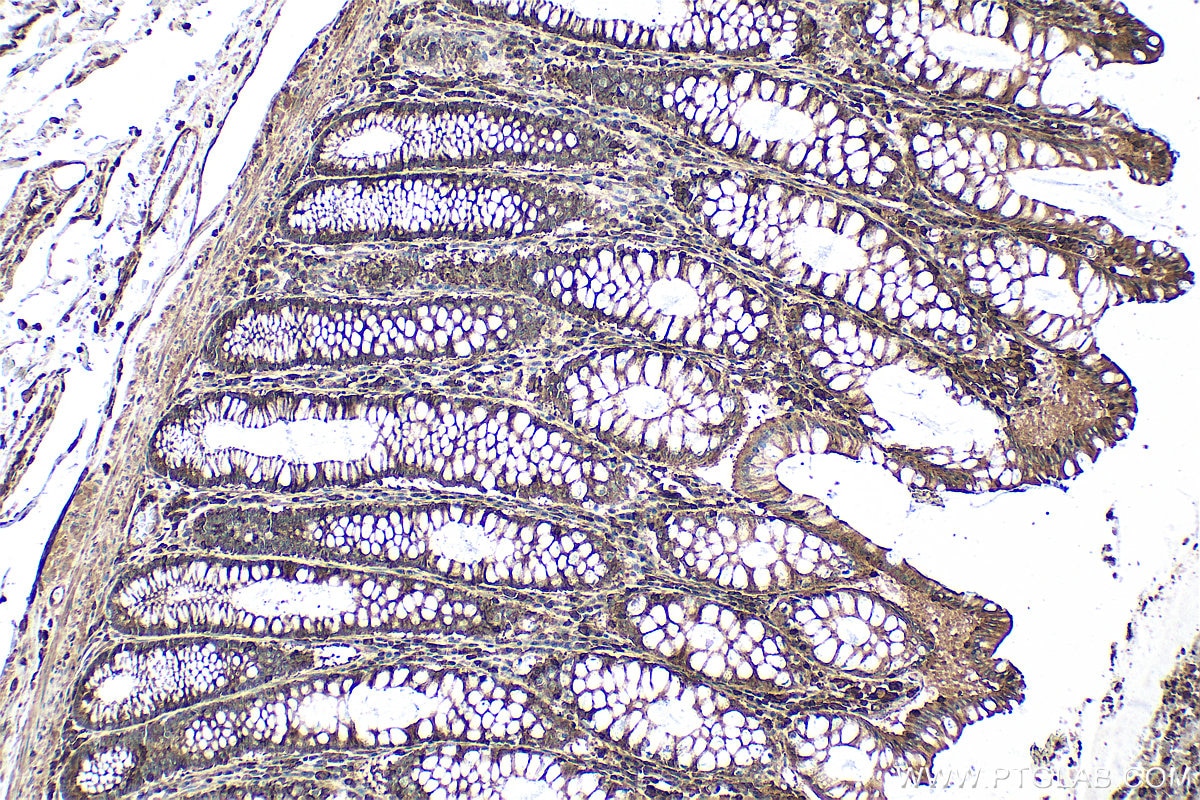
Immunohistochemistry (IHC) staining of human colon tissue using YTHDC2 Polyclonal antibody (27779-1-AP)
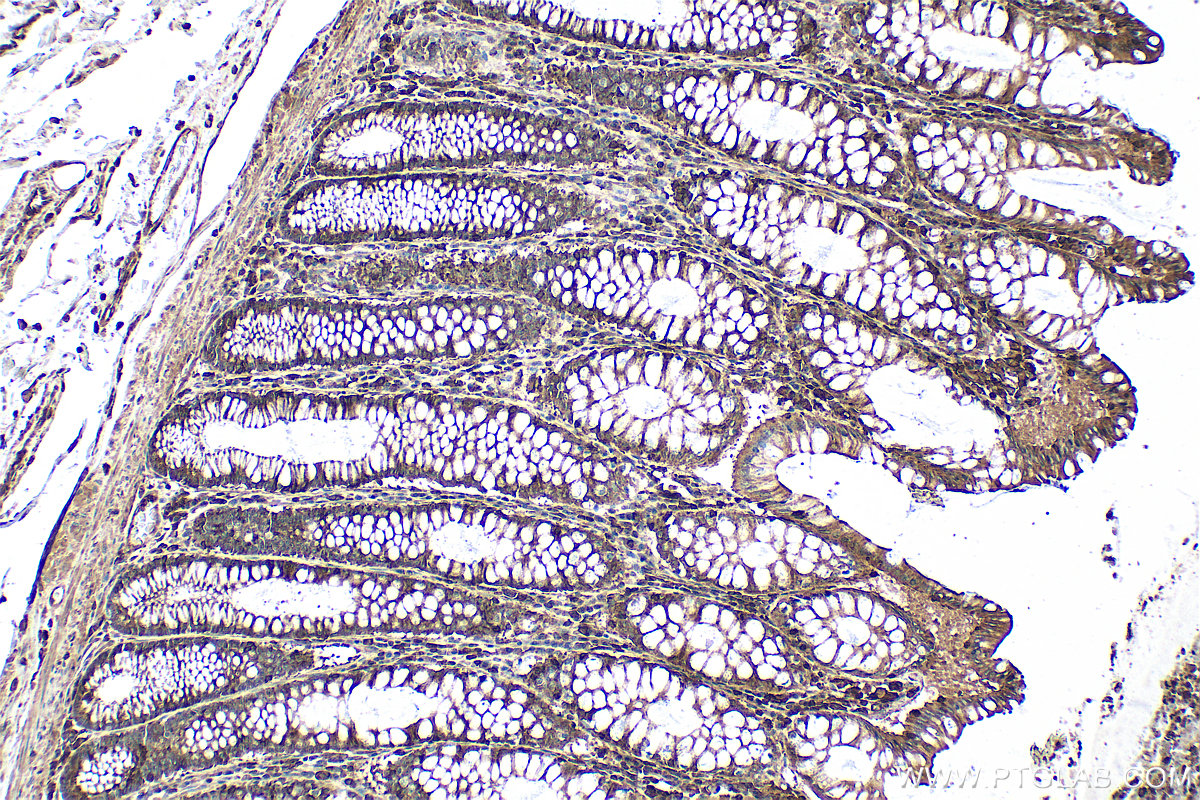
Immunohistochemistry (IHC) staining of human colon tissue using YTHDC2 Polyclonal antibody (27779-1-AP)

Tested Applications
| Positive WB detected in | HepG2 cells, HeLa cells, MCF-7 cells, MDA-MB-231 cells |
| Positive IP detected in | HeLa cells |
| Positive IHC detected in | rat testis tissue, human colon tissue, human stomach cancer tissue Note: suggested antigen retrieval with TE buffer pH 9.0; (*) Alternatively, antigen retrieval may be performed with citrate buffer pH 6.0 |
| Positive IF/ICC detected in | HepG2 cells |
| Positive FC (Intra) detected in | HeLa cells |
Recommended dilution
| Application | Dilution |
|---|---|
| Western Blot (WB) | WB : 1:1000-1:8000 |
| Immunoprecipitation (IP) | IP : 0.5-4.0 ug for 1.0-3.0 mg of total protein lysate |
| Immunohistochemistry (IHC) | IHC : 1:1000-1:4000 |
| Immunofluorescence (IF)/ICC | IF/ICC : 1:50-1:500 |
| Flow Cytometry (FC) (INTRA) | FC (INTRA) : 0.40 ug per 10^6 cells in a 100 µl suspension |
| It is recommended that this reagent should be titrated in each testing system to obtain optimal results. | |
| Sample-dependent, Check data in validation data gallery. | |
Published Applications
| KD/KO | See 4 publications below |
| WB | See 37 publications below |
| IHC | See 1 publications below |
| IF | See 10 publications below |
| IP | See 1 publications below |
| CoIP | See 1 publications below |
| RIP | See 2 publications below |
Product Information
27779-1-AP targets YTHDC2 in WB, IHC, IF/ICC, FC (Intra), IP, CoIP, RIP, ELISA applications and shows reactivity with human, mouse, rat samples.
| Tested Reactivity | human, mouse, rat |
| Cited Reactivity | human, mouse, rat, pig, sheep |
| Host / Isotype | Rabbit / IgG |
| Class | Polyclonal |
| Type | Antibody |
| Immunogen |
CatNo: Ag26690 Product name: Recombinant human YTHDC2 protein Source: e coli.-derived, PGEX-4T Tag: GST Domain: 1131-1430 aa of BC137285 Sequence: HSLFLRRMRAPSKPWSQVDEATIRAIIAVLSTEEQSAGLQQPSGIGQRPRPMSSEELPLASSWRSNNSRKSSADTEFSDECTTAERVLMKSPSPALHPPQKYKDRGILHPKRGTEDRSDQSSLKSTDSSSYPSPCASPSPPSSGKGSKSPSPRPNMPVRYFIMKSSNLRNLEISQQKGIWSTTPSNERKLNRAFWESSIVYLVFSVQGSGHFQGFSRMSSEIGREKSQDWGSAGLGGVFKVEWIRKESLPFQFAHHLLNPWNDNKKVQISRDGQELEPLVGEQLLQLWERLPLGEKNTTD Predict reactive species |
| Full Name | YTH domain containing 2 |
| Observed Molecular Weight | 160 kDa |
| GenBank Accession Number | BC137285 |
| Gene Symbol | YTHDC2 |
| Gene ID (NCBI) | 64848 |
| RRID | AB_2880970 |
| Conjugate | Unconjugated |
| Form | Liquid |
| Purification Method | Antigen affinity purification |
| UNIPROT ID | Q9H6S0 |
| Storage Buffer | PBS with 0.02% sodium azide and 50% glycerol, pH 7.3. |
| Storage Conditions | Store at -20°C. Stable for one year after shipment. Aliquoting is unnecessary for -20oC storage. 20ul sizes contain 0.1% BSA. |
Background Information
YTHDC2, also named as Probable ATP-dependent RNA helicase YTHDC2, is a 1430 amino acid protein, which belongs to the DEAD box helicase family. YTHDC2 specifically recognizes and binds N6-methyladenosine (m6A)-containing RNAs. M6A is a modification present at internal sites of mRNAs and some non-coding RNAs and plays a role in the efficiency of mRNA splicing, processing and stability.
Protocols
| Product Specific Protocols | |
|---|---|
| FC protocol for YTHDC2 antibody 27779-1-AP | Download protocol |
| IF protocol for YTHDC2 antibody 27779-1-AP | Download protocol |
| IHC protocol for YTHDC2 antibody 27779-1-AP | Download protocol |
| IP protocol for YTHDC2 antibody 27779-1-AP | Download protocol |
| WB protocol for YTHDC2 antibody 27779-1-AP | Download protocol |
| Standard Protocols | |
|---|---|
| Click here to view our Standard Protocols |
Publications
| Species | Application | Title |
|---|---|---|
Cell Mol Immunol Inhibition of METTL3 in macrophages provides protection against intestinal inflammation | ||
Mol Cell Spatiotemporal Proteomic Analysis of Stress Granule Disassembly Using APEX Reveals Regulation by SUMOylation and Links to ALS Pathogenesis. | ||
Sci Adv Regulation of telomere homeostasis and genomic stability in cancer by N 6-adenosine methylation (m6A). | ||
Nat Commun Fusobacterium nucleatum reduces METTL3-mediated m6A modification and contributes to colorectal cancer metastasis. | ||
Cancer Lett LIMK1 m6A-RNA methylation recognized by YTHDC2 induces 5-FU chemoresistance in colorectal cancer via endoplasmic reticulum stress and stress granule formation
| ||
Genes Dev YTHDC2 control of gametogenesis requires helicase activity but not m6A binding. |
Reviews
The reviews below have been submitted by verified Proteintech customers who received an incentive for providing their feedback.
FH Liz (Verified Customer) (10-02-2025) | Very clean and strong signal
|
FH Nikolett (Verified Customer) (07-23-2025) | I used this antibofy as 1:1000 for Western Blot, 1:300 for IHC and IF. Worked well without background, after overnight AB incubation in 3% BSA/PBS for WB. For IHC and IF I used NaCi pH6 for antigene retrieval and it worked nicely.
|
FH Maialen (Verified Customer) (02-10-2022) | YTHDC2 was immunoprecipitated from 4 million HCT15 cells lysate using 1μg 27779-1-AP (YTHDC2 antibody). Same amount of normal rabbit IgG was used as negative control. For IP confirmation, western blot with 27779-1-AP (YTHDC2 antibody) was perfomed at 1:1000 dilution incubated overnight at 4ºC. 10% of the whole cell lysate was loaded as input.
 |
FH Robert (Verified Customer) (01-24-2019) | 1. scrambled siRNA2. YTHDC2 siRNA12. YTHDC2 siRNA22. YTHDC2 siRNA3
 |